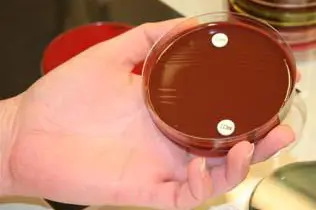
Prøvetakingsutstyr

Norsk Kvalitetsforbedring av laboratorieundersøkelser
Om Noklus
Noklus arbeider med kvalitetssikring av laboratorieundersøkelser i primær- og spesialisthelsetenesta.
Noklus arbeider med kvalitetssikring av laboratorieundersøkelser i primær- og spesialisthelsetenesta. Hovudkontoret ligg i Bergen (Haraldsplass diakonale sjukehus), medan laboratoriekonsulentar (bioingeniørar) og legespesialistar er tilknytta dei lokale helseforetaka.
Noklus har samarbeidsavtale med dei fire regionale helseforetaka.
Les meir på Noklus.no
Noklus arbeider for at laboratorieundersøkingar blir rekvirert, utført og tolka korrekt og i samsvar med pasienten sitt behov for utgreiing, behandling og oppfølging.
Noklus bidreg til dette ved å:
- besøke legekontor, sjukeheimar og heimetenester
- gi veiledning og opplæring
- arrangere kurs
- tilby e-læringskurs
- utarbeide og vedlikehalde nettbaserte laboratorieprosedyrer
- gi råd ved rekvirering og tolking av laboratorieprøver
- gi råd ved valg av laboratorieutstyr og analysemetodar
- hjelpe deltakarane til å kunne dokumentere eigen analysekvalitet
- sende ut kontrollprøver og gi tilbakemelding på eigen analysekvalitet
Deltakarane i Noklus:
- får hjelp til valg av analysemetodar
- kan dokumentere betre analysekvalitet
- har fått auka kunnskap om laboratoriearbeid
- kan når som helst kontakte sin lokale laboratoriekonsulent
Noklus arbeider for at personell i PHT skal ha kjennskap til viktige arbeidsrutiner ved sjukehuslaboratoria.

Laboratorierådgiver Mona Torvik

Laboratorierådgiver Ragnhild Eide Myren

Laboratoriespesialist Lutz Schwettmann
